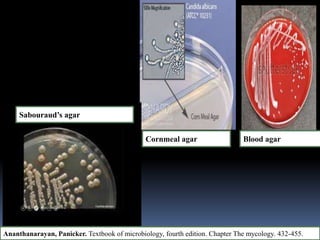
Sabouraud’s agar
Cornmeal agar Blood agar
Ananthanarayan, Panicker. Textbook of microbiology, fourth edition. Chapter The mycology. 432-455.

This document discusses candidiasis, caused by the yeast Candida. It begins with an introduction to mycology and the morphology of fungi. It then discusses candidiasis specifically, including its history, epidemiology, predisposing factors, pathogens involved, and pathophysiology. The document classifies the different types of candidiasis and discusses Candida in HIV patients. It covers the diagnosis and treatment of candidiasis and concludes with references.